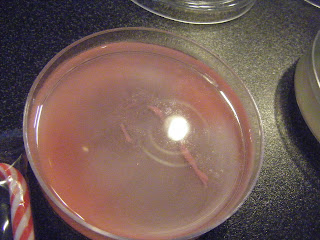

many of these items where found on livinglifeintentionally.blog and makinglearningfun.com sorry if i missed some places as i make some last year and they don't always have the makers mark !!! but please hare if you know .. HAPPY 2013 !!!
Saturday, December 29, 2012
Friday, December 21, 2012
The Gingerbread Man
Thanks for all following and Have a Merry Christmas and Happy New year . I think this will be my last Post until January 2013 !
Thursday, December 20, 2012
Reindeer
Here link to last years party with a few games we played .
Here many other ideas frm years past ! Merry christmas all
Tuesday, December 18, 2012
Wednesday, December 12, 2012
Candy Canes
They could smell the candy cane they said
Will the same thing happen with milk?
What child don't think of Christmas and think candy cane .
Tuesday, December 11, 2012
Subscribe to:
Comments (Atom)